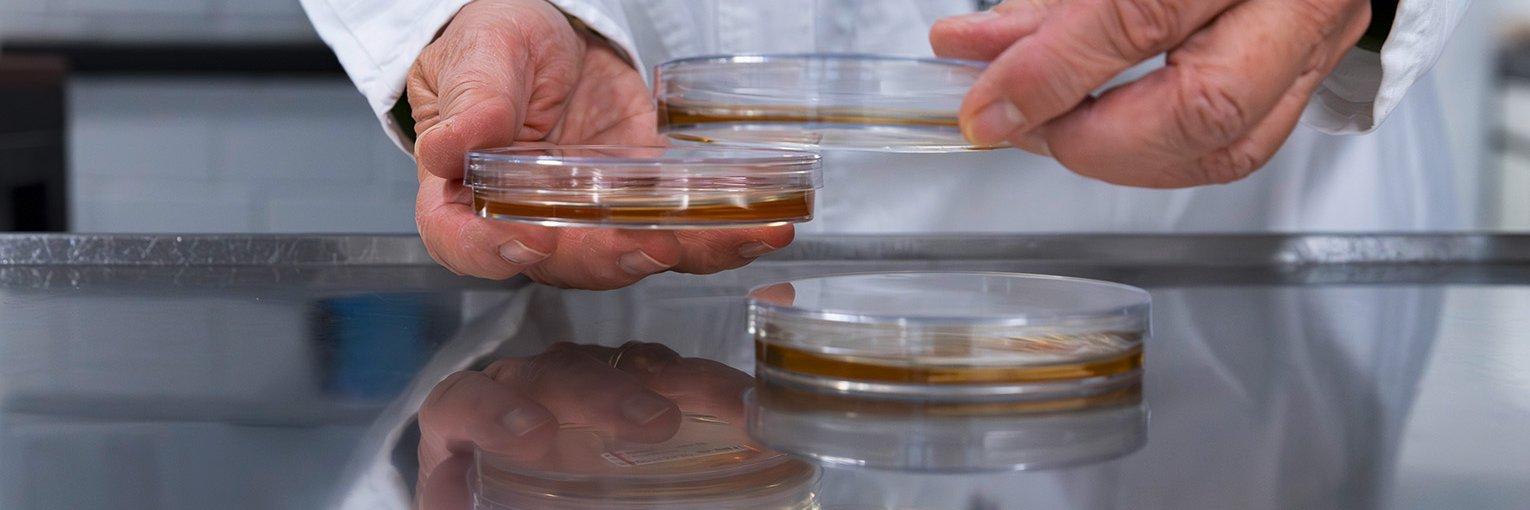

Die Trinkwasserverordnung
1975, vor mehr als 50 Jahren, wurde die erste Ausgabe der Trinkwasserverordnung (TrinkwV) am 31. Januar verfasst. Am 15. Februar 1976 trat sie in Kraft. Die Trinkwasserverordnung ist die Basis für die Überprüfung und die Güte, sie regelt alle Fragen zur Qualitätsüberwachung des in Deutschland verteilten Trinkwassers. Seitdem wird so die Genussfähigkeit und Sauberkeit dieses wichtigsten Lebensmittels garantiert.
In Abhängigkeit von der Menge des verteilten Wassers in einem Versorgungsgebiet bzw. der abgegebenen Menge eines Wasserwerks müssen verschiedenste Parameter in unterschiedlicher Häufigkeit untersucht werden. Dabei gilt die Faustregel: „Je größer die Wassermenge, desto häufiger muss untersucht werden.“
Die TrinkwV regelt neben der Häufigkeit auch, welche Parameter zu untersuchen sind, und legt Grenzwerte für diese Parameter fest, die eingehalten werden müssen. Die Parameter umfassen dabei verschiedenste Aspekte, die für die Qualität und Genusstauglichkeit des Trinkwassers ausschlaggebend sind.
So müssen neben den mikrobiologischen Parametern grundlegende wasserchemische Kenngrößen, bspw. der pH-Wert, Trübung und Färbung, Gehalte von gelösten Metallen und anderen Ionen sowie verschiedene Spurenstoffe, bspw. Pflanzenschutzmittel, polyzyklische aromatische Kohlenwasserstoffe (PAK) und per- und polyfluorierte Alkylsubstanzen (PFAS), regelmäßig überwacht werden.

Biologische Analytik
Mikrobiologische Parameter Trinkwasserverordnung
Die Trinkwasserverordnung gibt verschiedene mikrobiologische Parameter zur Überprüfung vor. Wir als Labor Westfälische Wasser- und Umweltanalytik sind für die Untersuchung der mikrobiologischen Parameter der Trinkwasserverordnung akkreditiert. Neben bakteriellen Parametern wie Koloniezahlen, E. coli / Coliforme Bakterien, Enterokokken, Clostridium perfringens, Legionellen, Pseudomonas aeruginosa zählt auch die Untersuchung auf somatische Coliphagen dazu.
Wir nehmen in regelmäßigen Abständen erfolgreich an Ringversuchen teil und haben langjährige Erfahrungen mit verschiedenen mikrobiologischen Untersuchungsverfahren. Auch bei Störfällen oder besonderen Fragestellungen beraten wir nach Bedarf kompetent und können bei weiteren, über die Trinkwasserverordnung hinausreichenden Untersuchungsverfahren unterstützen. mehr zu unserer Beratung

Mikrobiologische Analytik
Wir bieten alle mikrobiologischen Roh-, Rein- und Filtratwässer-Untersuchungen an, nach Wunsch und in Abstimmung mit unseren Kunden und ihren unterschiedlichen Bedürfnissen.
Unsere Leistungen
Durchflusszytometrie
Mithilfe der Durchflusszytometrie (Durchflusszellmessung) lässt sich innerhalb kürzester Zeit die Zahl aller in einer Wasserprobe enthaltenen Bakterien (Gesamtzellzahl) bestimmen. Die Analyse ist kultivierungsunabhängig und dauert nur wenige Minuten, sodass das Verfahren ergänzend zu den Kulturverfahren einen wertvollen Beitrag in der mikrobiologischen Wasseranalytik leisten kann, insbesondere bei der Detektion plötzlicher Änderungen.
Die WWU bietet ihren Kunden die Analytik der Durchflusszytometrie zur Bestimmung der Gesamt- und Intaktzellzahl an. Darüber hinaus können auch weitere Parameter mithilfe der Durchflusszytometrie bestimmt werden (z. B. Zahl der LNA- und HNA-Bakterien, Aufkeimungspotenzial).

Ausgewählte Anwendungsbeispiele

Chemische Analytik
Dr. André Liesener
Leiter chemische Analytik, Spurenstoffexperte
Die Verbesserung der Laborgerätetechnik spielt eine zentrale Rolle in der Spurenstoffthematik. In den 1990er-Jahren konnte in Milligramm pro Liter (mg/l) gemessen werden, heute sind Nachweise in Mikro- und sogar Nanogramm pro Liter alltäglich. Als erstes waren es Pflanzenschutzmittel, die im Wasser nachgewiesen wurden. Es folgten Industriechemikalien, Pharmazeutika und Haushaltschemikalien. Wir beschäftigen uns mit den Analyse- und Messmethoden und den dahinterliegenden grundsätzlichen Konzepten (Target-Analyse und Non-Target-Analyse) und den Möglichkeiten der Bewertung.
Was macht die chemische Analytik bei der WWU besonders?
Die WWU bietet ihren Kunden ein breites Spektrum verschiedenster Analyseverfahren an, mit denen unterschiedlichste Fragestellungen beantwortet werden können. Ein zentraler Bestandteil unseres Leistungsspektrums ist dabei die Bestimmung der in den gesetzlichen Vorgaben (z. B. Trinkwasserverordnung) geforderten Parameter.
Über diesen Mindestumfang hinaus bietet die WWU aber auch die Möglichkeit der Bestimmung vieler weiterer Parameter an. Dazu gehören unter anderem Metalle, bspw. die Lanthanoide, oder Spurenstoffe aus den Bereichen der Arzneimittelwirkstoffe und Industrie- und Haushaltschemikalien sowie deren Abbauprodukte.
Ein weiterer Schwerpunkt, der die zielgerichteten quantitativen Verfahren zur Spurenstoffbestimmung ergänzt, ist das Spurenstoffscreening. In den dazu gehörenden Verfahren wird ein sehr breites Spektrum verschiedenster Spurenstoffe gleichzeitig erfasst, und sie ermöglichen es so, einen schnellen Überblick über eine Belastungssituation zu erhalten.
Neben diesen stoffzentrierten Analyseverfahren, die primär Stoffe in der Wasserphase erfassen, bietet die WWU auch ein umfassendes Spektrum von Analyseverfahren zur Charakterisierung von Aktivkohlen an.
Dabei werden sowohl Materialeigenschaften der Aktivkohle selbst erfasst als auch Leistungsparameter hinsichtlich ihrer Effektivität zur Spurenstoffelimination bestimmt.
Alle Analyseverfahren sind dabei akkreditiert und werden im Rahmen unseres Qualitätsmanagementsystems streng kontrolliert.
Spurenstoffscreening
Neben den in der Trinkwasserverordnung verpflichtend zur Untersuchung geforderten Parametern aus der Kategorie der Spurenstoffe wie Pflanzenschutzmittel, polyzyklische aromatische Kohlenwasserstoffe (PAK) und per- und polyfluorierte Alkylsubstanzen (PFAS) kommt noch eine Vielzahl anderer menschengemachter Stoffe in der aquatischen Umwelt vor.
Sie können somit auch von Bedeutung für das Trinkwasser sein. Prominente Beispiele sind Arzneimittelwirkstoffe oder Industrie- und Haushaltschemikalien, die in Kläranlagen zum Teil nur schlecht abgebaut werden können und so in Oberflächengewässer und den Wasserkreislauf gelangen.
Dieses ohnehin sehr breite Spektrum an verschiedensten Stoffen wird noch dadurch vergrößert, dass aus den ursprünglich eingesetzten Stoffen noch Abbauprodukte entstehen können (zum Teil gewollt, zum Teil als Produkte natürlich ablaufender Abbauprozesse), die ebenfalls im Wasserkreislauf vorhanden sind.
Da eine zielgerichtete Messung dieser Vielzahl an möglicherweise vorhandenen Stoffen in der Regel nicht möglich ist, kommt ungerichteten Analyseverfahren, die ein breites Spektrum dieser Substanzen gleichzeitig erfassen können, eine zunehmende Bedeutung zu.
In diesen sogenannten Screeningverfahren werden die Spurenstoffe in erster Linie qualitativ erfasst, d. h., es wird eine Aussage getroffen, ob ein Stoff in einer Wasserprobe vorhanden ist.
Eine Quantifizierung hinsichtlich der Konzentration ist in der Regel nur sehr eingeschränkt möglich und muss durch eine nachgelagerte gezielte Gehaltsbestimmung der Substanz erfolgen.
Massenspektrometrie
Die Massenspektrometrie in Kopplung mit gas- oder flüssigkeitschromatografischen Trennverfahren ist das Hauptarbeitspferd für die Bestimmung von Spurenstoffen. Nur mit diesen Verfahren können organische Spurenstoffe mit der notwendigen Nachweisstärke routinemäßig im Konzentrationsbereich von Mikrogramm bis Nanogramm pro Liter bestimmt werden.
Für eine Messung wird die Probe in das Analysensystem eingespritzt, und die Bestandteile der Probe (die zu untersuchenden Stoffe = Analyten sowie die Hintergrundbestandteile = Matrix) werden zunächst im Chromatografen voneinander getrennt. Das Massenspektrometer dient dabei als Detektor für die Analyten.
In diesem Gerät werden die Analyten nach ihren Molekülmassen getrennt, und die Menge der vorhandenen Analytteilchen, die den Detektor erreichen, wird gemessen. Diese Messsignale sind dann proportional zur Konzentration der jeweiligen Stoffe in der Probe.
Zusätzlich ist es oft möglich, über sog. Fragmentierungsreaktionen im Massenspektrometer Informationen über die Molekülstruktur eines Analyten zu erhalten und so die korrekte Identität des detektierten Stoffs abzusichern.
Überwachung Aufbereitungsstoffe – Wertbeständigkeit Aktivkohle
Neue und strengere Anforderungen an die Trinkwasserqualität können zu steigenden Anforderungen an die Aufbereitung führen. Insbesondere mit Blick auf organische Spurenstoffe rückt der Einsatz von Aktivkohle wieder verstärkt in den Fokus.
Mit der akkreditierten Aktivkohleanalytik der WWU können wir unsere Kunden bei der Planung und dem Betrieb von Aktivkohleanlagen gut unterstützen. Diese Analytik umfasst neben physikalisch-chemischen Untersuchungen auch Tests zu den Adsorptionseigenschaften von Aktivkohlen.
Unsere Daten helfen bei der Auswahl der passenden Aktivkohle, der Wareneingangskontrolle der Kohlelieferung und der Bewertung der Adsorptionskapazität von bestehenden Anlagen unserer Kunden. Wir unterstützen damit bei einem möglichst effizienten Einsatz der Aktivkohle in Ihrem Betrieb.
Daneben bieten wir Untersuchungen für weitere gängige Aufbereitungsstoffe an, bspw. Natronlauge, Natriumhypochlorit oder Phosphat, und garantieren so eine saubere Wareneingangskontrolle für diese Stoffe im Betrieb.
Außerdem unterstützen wir gerne beratend bei der Planung von Versuchen zu weitergehenden Aufbereitungsverfahren in Ihrem Wasserwerk. mehr zu unserer Beratung